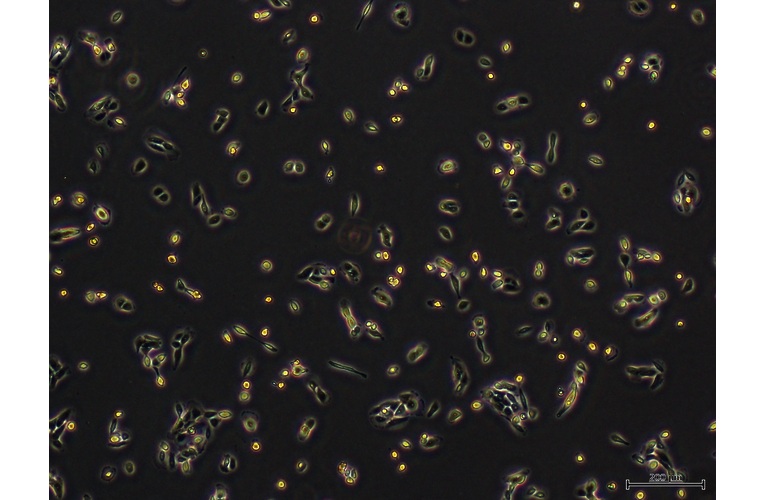

CELL LINES
Contributor Information
- Name John Isaacs
- Institute Johns Hopkins University
Tool Details
- Tool name: R-3327 AT.2 cell line
- Tool type: Cell Lines
- Cancer type: Genitourinary cancer
- Disease: Cancer
- Model: Cancer Model
- Description: AT-2 originates from the spontaneous tumor (R3327) of the prostate identified by W.F. Dunning in a 22 month-old inbred Copenhagen male rat in 1961. R3327 has been maintained by continuous serial passage in rats for many years. AT-2 was identified in 1981 and was the second of such anaplastic tumors to arise. Following subcutaneous transplantation in syngeneic male rats, AT-2 forms solid sheets of malignant cells with no indication of glandular function. These tumors are androgen-independent and grow continuously with a doubling time of approximately 2.5 days. AT-2 exhibits a low to moderate metastatic ability (<20% of rats inoculated sub-cutaneously develop distant metastases). The AT-2 subline can be used to study the effects of various types of cancer therapies on prostate cells.
- Research area: Cancer; Drug development
- Cellosaurus ID: CVCL_L303
- For Research Use Only
Related Tools
References
- • Musialik et al. 2013. Oncol Rep. 29(5):1789-96. PMID: 23467722.
- • Isaacs et al. 1986. Prostate. 9(3):261-81. PMID: 3774632.

